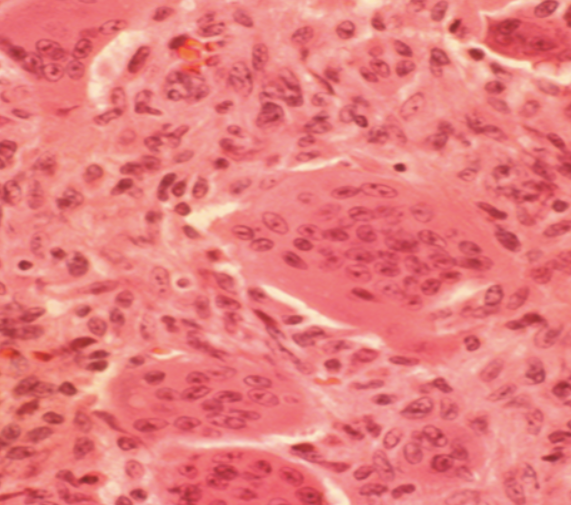

Describe metastatic cancer of bone?
What is the pathophysiology of bony mets?
What is the prognosis of pts with metastatic disease with thyroid, prostate, breast, kidney and lung?

Name associated conditions of metastatic disease?
describe the mechanism of metastasis?

What are the symptoms of metastatic disease?
Describe the workup for a pt with suspected metastatic diseasee?

What is the goal of tx in metastatic disease?
What is the tx of metastatic disease?
Non operative
Operative
What is the tx for metastatic spinal lesion?
Non operative
Operative
Are there any scoring systems to help decide prognosis of spinal mets and so tx?

What is a Giant cell tumour?

Describe the malignancy of gct?
What are the symptoms of GCT?
O/E
What is seen on imaging a GCT?
Xrays
Bone scan
MRI

Describe the histology of GCT?
What is the tx of GCT?
Non operative
Operative
What is Ewing’s sarcoma?

What is the prognosis of Ewing’s sarcoma?
Poor prognostic factors
What is the symptoms of Ewing’s sarcoma?
O/E

What are the signs of Ewing’s sarcoma on imaging?
Xray
Bone Scan
MRI
CT chest

What is seen on lab results with Ewing’s sarcoma?
What is seen on histology with Ewing’s sarcoma?

Describe the tx for ewing’s sarcoma?